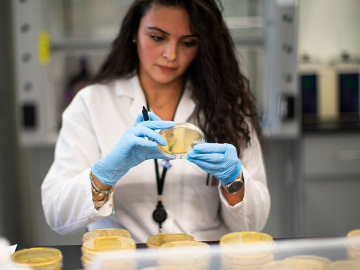
A researcher works in a lab that is developing testing for the COVID-19 coronavirus at Hackensack Meridian Health Center for Discovery and Innovation on February 28, 2020 in Nutley, New Jersey.  Image: Kena Betancur/Getty

Jamie Bay Nishi
Jamie Bay Nishi is director of the Global Health Technologies Coalition (GHTC), a coalition of 30 nonprofit organizations, academic institutions, and aligned businesses advancing policies to accelerate the creation of new drugs, vaccines, diagnostics, and other tools that bring healthy lives within reach for all people.